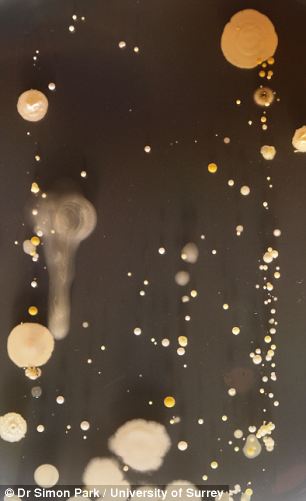
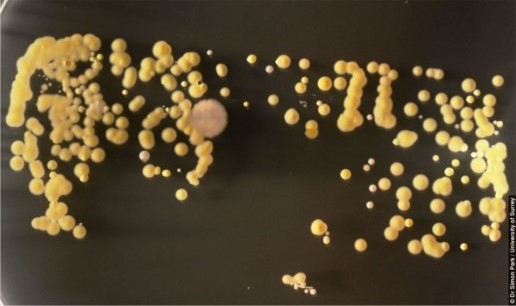

Poznáte to. Spolu so sklenenými plochami na našich zariadeniach pribudla do nášho života ďalšia činnosť, čistenie skla. Musíte uznať, že takto vyčistený iPhone, iPod či iPad je skutočne nádherný a pôsobí, akoby ste si ho práve zakúpili a rozbalili. Napriek tomu však váš telefón nie je až tak úplne čistý, ako si myslíte a po zhliadnutí nasledujúcej série fotografií nadobudnete pocit, že by bolo predsa len lepšie zobrať silnejší dezinfekčný prostriedok. Za sériou nepekných fotografií stojí tím výskumníkov z britskej University of Surrey.
Vedecký tím univerzity sa rozhodol pre svoj experiment pod záštitou docenta Dr. Simona Parka použiť niekoľko dlhodobo používaných smartfónov vrátane Apple iPhone. Tieto prístroje boli následne zatlačené prednou stranou k Petriho miskám a už po troch dňoch sa pred očami študentov objavili úkazy, ktoré následne vyfotografovali a upozornili na ne verejnosť. „Je to neobvyklý krok, ale ide o veľmi efektívny spôsob, ako našich študentov oboznámiť s mikrobiológiou v každodennom, praktickom živote. Mikrobiológia ako súčasť každodenného života je veľmi prehliadaná,“ tvrdí o výskume Dr. Simon Park.


Tieto baktérie sa na telefón prenášajú „stylusom od Boha“, ľudským prstom. Nimi totiž chytáme všetko a každá správa, prihlásenie sa do App Store či kontrolovanie e-mailov, zanecháva naše biologické stopy aj potom, ako telefón vyčistíme handričkou. Aj keď drvivá väčšina baktérii je neškodná, stále je medzi nimi možné nájsť škodcov, napríklad Staphylococcus Aureus, ktorá je príčinou mnohých stafylokokových infekcií. Tvrdí sa, že až 20% svetovej populácie je dlhodobým nosičom baktérie, ktorá sa mnohokrát ukrýva v nosových dierkach.
„Baktéria Staphylococcus Aureus sa väčšinou nachádza v nozdrách, preto stačí jemné poškrabanie sa v nose, okamžité odpísanie SMS správy a patogén je na vašom smartfóne. Na našich fotkách môžete jasne vidieť obrysy telefónov, no zvyšok dosky je pokrytý rozširujúcou sa baktériou Bacillus Mycoides. Takýto rast je pre túto baktériu skutočne unikátny a pretože jej prirodzeným prostredím pôda, vieme, že tento telefón alebo jeho používateľ bol nedávno v kontakte s pôdou. Každý telefón vypráva svoj príbeh. Z týchto výsledkov môžeme povedať, že mobilný telefón si nepamätá len telefónne čísla, ale taktiež ukrýva aj históriu nášho osobného a fyzického kontaktu s inou osobou, pôdou alebo inou hmotou.“

Poznáte to. Spolu so sklenenými plochami na našich zariadeniach pribudla do nášho života ďalšia činnosť, čistenie skla. Musíte uznať, že takto vyčistený iPhone, iPod či iPad je skutočne nádherný a pôsobí, akoby ste si ho práve zakúpili a rozbalili. Napriek tomu však váš telefón nie je až tak úplne čistý, ako si myslíte a po zhliadnutí nasledujúcej série fotografií nadobudnete pocit, že by bolo predsa len lepšie zobrať silnejší dezinfekčný prostriedok. Za sériou nepekných fotografií stojí tím výskumníkov z britskej University of Surrey.
Vedecký tím univerzity sa rozhodol pre svoj experiment pod záštitou docenta Dr. Simona Parka použiť niekoľko dlhodobo používaných smartfónov vrátane Apple iPhone. Tieto prístroje boli následne zatlačené prednou stranou k Petriho miskám a už po troch dňoch sa pred očami študentov objavili úkazy, ktoré následne vyfotografovali a upozornili na ne verejnosť. „Je to neobvyklý krok, ale ide o veľmi efektívny spôsob, ako našich študentov oboznámiť s mikrobiológiou v každodennom, praktickom živote. Mikrobiológia ako súčasť každodenného života je veľmi prehliadaná,“ tvrdí o výskume Dr. Simon Park.


Tieto baktérie sa na telefón prenášajú „stylusom od Boha“, ľudským prstom. Nimi totiž chytáme všetko a každá správa, prihlásenie sa do App Store či kontrolovanie e-mailov, zanecháva naše biologické stopy aj potom, ako telefón vyčistíme handričkou. Aj keď drvivá väčšina baktérii je neškodná, stále je medzi nimi možné nájsť škodcov, napríklad Staphylococcus Aureus, ktorá je príčinou mnohých stafylokokových infekcií. Tvrdí sa, že až 20% svetovej populácie je dlhodobým nosičom baktérie, ktorá sa mnohokrát ukrýva v nosových dierkach.
„Baktéria Staphylococcus Aureus sa väčšinou nachádza v nozdrách, preto stačí jemné poškrabanie sa v nose, okamžité odpísanie SMS správy a patogén je na vašom smartfóne. Na našich fotkách môžete jasne vidieť obrysy telefónov, no zvyšok dosky je pokrytý rozširujúcou sa baktériou Bacillus Mycoides. Takýto rast je pre túto baktériu skutočne unikátny a pretože jej prirodzeným prostredím pôda, vieme, že tento telefón alebo jeho používateľ bol nedávno v kontakte s pôdou. Každý telefón vypráva svoj príbeh. Z týchto výsledkov môžeme povedať, že mobilný telefón si nepamätá len telefónne čísla, ale taktiež ukrýva aj históriu nášho osobného a fyzického kontaktu s inou osobou, pôdou alebo inou hmotou.“

Pro mne je ale důležité to, že můj první iPhone v létě 2007 mne zbavil nepříjemného ekzému na palci a ukazováčku pravé ruky, se kterým si přes rok lámala hlavu moje kožní lékařka. Dnes s jistotou mohu potvrdit, že to způsobovala ostrá hranatá pokadmiovaná tlačítka Sony Ericsson P990i, který jsem používal necelé 2 roky před prvním iPhonem. Jakmile jsem onen SE dal do šuplíku a nahradil ho iP, problémy do měsíce sami smizely.
Amiga 500 – tak to je husté!
Amiga 500 – tak to je mazec! :)
Clanok velmi chvalim obsahovo, ale napisat do clanku slovo „vypráva“ je pre mna nepriatelne, ako keby som ja napisal clanok a pouzil v nom slovo „rečuje“. :-)
Amigo s tim kadimem na tlacitkach bych byl opatrny… Nemohlo to byt spis jako u kolegy- ten se taky zbavil mozolu a ekzemu na ruce, kdyz si nasel slecnu….
@Former.Billionaire ty si mu teda dal :-)
Former.Billionaire: máte asi s kolegou důvěrný vztah, když se ti svěřuje s takovými věcmi :-)))
Amiga 500: velmi dobrý nick! Amiga byla skvělá, těch „progamesených“ nocí! Rád na to vzpomínám. Měl jsem pak i Amiga 1200, ale ta 500 byla klasika! Je to nostalgie jako prase!